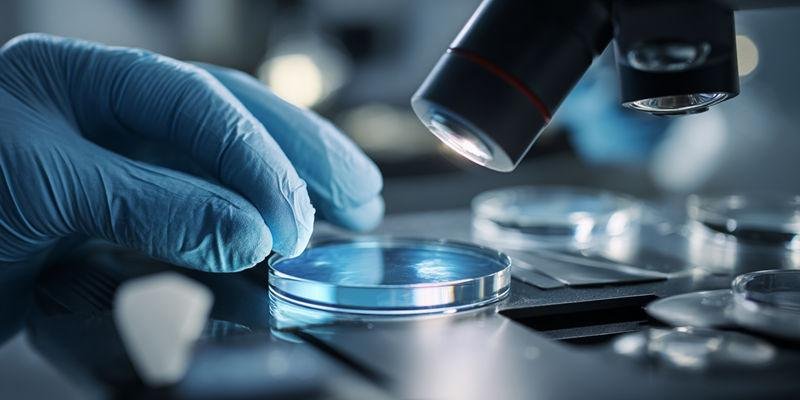
What Surface Flatness Polishing Specifications of Quartz Disc Define Precision Optical Quality?

La calidad precisa de la superficie y las especificaciones de pulido determinan el rendimiento de cada componente óptico en aplicaciones de alta precisión. Las imperfecciones superficiales, como arañazos o astillas, reducen la calidad y pueden limitar las aplicaciones láser. Los ingenieros necesitan especificaciones claras de la superficie y tolerancias de calidad de la superficie para satisfacer las necesidades de los componentes ópticos y los sistemas láser. Microqsil ofrece discos de cuarzo en varios grados, cada uno diseñado para usos ópticos y láser específicos. El acabado superficial, la rugosidad y el número de arañazos definen los defectos admisibles. La inspección visual y los sólidos protocolos de inspección garantizan que cada disco óptico cumpla los estrictos requisitos de especificación y calidad para aplicaciones láser de precisión. El cumplimiento de las especificaciones de calidad de la superficie de los discos de cuarzo pulidos óptica de precisión admite sistemas ópticos de alta precisión.
Principales conclusiones
La calidad de la superficie y las especificaciones de pulido son cruciales para un rendimiento óptimo en óptica de precisión. Unas normas claras ayudan a evitar defectos que pueden afectar a las aplicaciones láser.
Los ingenieros deben utilizar métodos de medición interferométrica para evaluar con precisión la planitud de la superficie. Así se garantiza que los discos de cuarzo cumplan estrictas especificaciones ópticas.
Los parámetros de pulido, como la presión y la velocidad, influyen significativamente en la rugosidad de la superficie. El ajuste de estos factores puede mejorar la calidad de los componentes ópticos acabados.
Comprender las normas de scratch-dig es esencial para mantener la calidad estética. Los ingenieros deben respetar las especificaciones para garantizar elementos ópticos de alto rendimiento.
La aplicación del control estadístico de procesos (CEP) ayuda a mantener la uniformidad del pulido. Este enfoque reduce los defectos y garantiza un rendimiento óptico uniforme en todos los lotes.
¿Qué especificaciones de pulido de planitud superficial del disco de cuarzo definen la calidad óptica de precisión?
La planitud de la superficie es un parámetro crítico en disco de cuarzo pulido de superficies especificaciones de calidad óptica de precisión Los ingenieros confían en las mediciones precisas de planitud para garantizar que los componentes ópticos cumplen las exigentes especificaciones ópticas y ofrecen un rendimiento constante. La planitud precisa de la superficie influye directamente en la calidad de las aplicaciones láser y en la calidad general de la superficie del producto acabado.
Métodos interferométricos de medición de la planitud según ISO 10110-5
La medición interferométrica proporciona el método más preciso para evaluar la planitud de la superficie en ópticas de precisión con especificaciones de calidad de superficie de pulido de discos de cuarzo. Los ingenieros ópticos utilizan interferómetros Fizeau o Twyman-Green para medir las desviaciones con respecto a una superficie de referencia, siguiendo las normas ISO 10110-5. Estos instrumentos detectan incluso las imperfecciones más pequeñas de la superficie, con análisis de desplazamiento de fase que consiguen una resolución vertical de hasta 1 nanómetro.
El proceso consiste en colocar el disco de cuarzo bajo el interferómetro y analizar los patrones de interferencia resultantes. Estos patrones, a menudo denominados anillos de Newton, revelan tanto la forma general como las desviaciones localizadas de la superficie. Los ingenieros interpretan estos patrones para determinar si el disco cumple la especificación de planitud requerida, como λ/10 o λ/20, habituales en componentes ópticos de alta precisión.
La inspección interferométrica garantiza que sólo los discos con defectos admisibles pasan el control de calidad, lo que reduce el riesgo de problemas de rendimiento en los sistemas láser y de imagen.
Punto clave | Causa | Efecto |
|---|---|---|
Métodos interferométricos | Utilización de configuraciones Fizeau/Twyman-Green | Detectar desviaciones superficiales a escala nanométrica |
Cumplimiento de la norma ISO 10110-5 | Protocolos de medición normalizados | Evaluación fiable y repetible de la planitud |
Análisis de cambio de fase | Adquisición de datos de alta resolución | Detección precoz de imperfecciones superficiales |
Parámetros del proceso de pulido que controlan la precisión de la figura superficial
Los parámetros del proceso de pulido desempeñan un papel vital en la consecución de la precisión de la figura superficial requerida para las especificaciones de calidad de la superficie de pulido de discos de cuarzo óptica de precisión. Entre los factores clave se incluyen la concentración de trietanolamina (TEA), la presión de pulido y la velocidad de rotación de la platina. El ajuste de estos parámetros permite a los ingenieros controlar la velocidad de eliminación de material y minimizar las imperfecciones de la superficie.
Aumentar la presión de pulido mejora la tasa de eliminación de material y reduce la rugosidad de la superficie. Por ejemplo, aumentar la presión de 49 N a 98 N puede mejorar la relación señal-ruido (SNR) de la tasa de arranque de material hasta en 10,8%. Las velocidades más altas de la platina, como el aumento de 30 rpm a 90 rpm, también mejoran la eficacia del contacto abrasivo, aumentando la SNR del MRR en 11,1%. El control cuidadoso de la concentración de TEA garantiza una sinergia químico-mecánica óptima durante el pulido, lo que resulta esencial para mantener la calidad de la superficie.
Los ingenieros supervisan de cerca estos parámetros para garantizar que cada disco cumple las especificaciones de superficie requeridas y supera la inspección visual.
Resumen de los parámetros clave del proceso:
La concentración óptima de TEA potencia la acción químico-mecánica.
El aumento de la presión de pulido y de la velocidad de la platina mejora los índices de eliminación.
El control coherente de los parámetros reduce las imperfecciones de la superficie.
Potencia vs. Irregularidad: Comprender los componentes de las figuras de superficie
La potencia y la irregularidad representan dos componentes principales del error de forma de la superficie en las especificaciones de calidad de la superficie de pulido de discos de cuarzo óptica de precisión. La potencia describe la desviación global de la curvatura con respecto a una superficie de referencia, mientras que la irregularidad mide las desviaciones localizadas de la forma. Ambos factores influyen en el rendimiento óptico de los discos de cuarzo y determinan si el disco cumple la especificación requerida.
Los ingenieros evalúan la potencia y la irregularidad mediante patrones de interferencia generados durante las pruebas interferométricas. La potencia afecta a la capacidad de enfoque del componente óptico, mientras que la irregularidad puede introducir distorsión del frente de onda y reducir la calidad de la imagen. Mediante el análisis de estos patrones, los ingenieros pueden separar y cuantificar cada componente, asegurándose de que el disco cumple los requisitos de planitud y calidad superficial.
Comprender la diferencia entre potencia e irregularidad ayuda a los ingenieros a establecer especificaciones superficiales adecuadas y minimizar los defectos admisibles en los componentes ópticos.
Componente | Definición | Impacto en la calidad de la superficie |
|---|---|---|
Potencia | Desviación de la curvatura respecto a la superficie de referencia | Altera el enfoque y el rendimiento óptico |
Irregularidad | Desviación de forma localizada | Provoca distorsión del frente de onda, reduce la calidad |
¿Qué normas de calidad de pulido de superficies de discos de cuarzo se aplican a los discos ópticos?
Rasca y escarba establecen la norma para la calidad cosmética de las superficies de los componentes ópticos. Estas especificaciones ayudan a los ingenieros a controlar las imperfecciones superficiales que pueden afectar a las aplicaciones láser y al rendimiento óptico general. Comprender los métodos de inspección y los procesos de pulido correctos garantiza que cada disco de cuarzo cumpla la calidad de superficie requerida.
MIL-PRF-13830B Interpretación y aplicación de la norma Scratch-Dig
La norma MIL-PRF-13830B utiliza un sistema de dos números para definir la anchura máxima admisible de los arañazos y el diámetro de excavación en una superficie óptica. Los números más bajos de este sistema indican una mayor calidad, con valores como 20/10 reservados para elementos de alta precisión y 80/50 para óptica básica. Esta norma limita cada pieza a un máximo de un arañazo de 0,001 mm de ancho y una excavación de 0,05 mm de diámetro, lo que es más estricto que la norma ISO 10110.
Los ingenieros interpretan estos números durante la inspección visual para asegurarse de que la superficie cumple la especificación requerida. Comparan los defectos observados con las normas maestras, confirmando que el disco no supera el número o el tamaño permitidos de arañazos y excavaciones. Este proceso ayuda a mantener una calidad de superficie uniforme en todos los discos ópticos.
Estándar Scratch-Dig | Descripción |
|---|---|
Sistema de dos números | Indica el tamaño máximo de rayado (micras) y el diámetro óptimo de excavación (centésimas de milímetro) |
Indicación de calidad | Los números más bajos indican mayor calidad; "0-0" indica superficies muy libres de arañazos. |
Definición del rasguño | Un defecto significativamente mayor que su anchura |
Definición de excavación | Defecto en forma de fosa de longitud y tamaño aproximadamente equivalentes. |
Valores regulares | Oscila entre 80/50 para ópticas básicas y 20/10 o menos para elementos de alta precisión. |
Métodos de inspección: Técnicas de microscopía de campo oscuro frente a las de campo claro
Los ingenieros utilizan tanto la microscopía de campo oscuro como la de campo claro para inspeccionar las superficies de los discos de cuarzo en busca de imperfecciones. La microscopía de campo claro proporciona una imagen brillante y funciona bien para detectar defectos de gran superficie o diferencias de color, mientras que la microscopía de campo oscuro es excelente para revelar pequeñas partículas y arañazos finos resaltándolos sobre un fondo oscuro.
La microscopía de campo oscuro utiliza luz que no entra directamente en la lente del objetivo, lo que la hace especialmente eficaz para identificar pequeñas imperfecciones superficiales. Este método aumenta el contraste, lo que permite a los ingenieros detectar pequeñas grietas o partículas que podrían pasar desapercibidas con la inspección de campo claro. El campo claro sigue siendo útil para los defectos de patrón, pero el campo oscuro es superior para detectar los defectos más pequeños.
Característica | Imágenes de campo claro | Imágenes de campo oscuro |
|---|---|---|
Brillo de la imagen | Mayor luminosidad general | Menor luminosidad general |
Detección de defectos | Mejor para los defectos de patrón | Superior para la detección de partículas pequeñas |
Análisis de superficies | Bueno para diferencias de color/contraste | Excelente para la rugosidad superficial |
Área de cobertura | Mejor para defectos de gran superficie | Destaca los pequeños cambios topográficos |
Limitaciones | Abrumado por fondos reflectantes, no detecta partículas muy pequeñas, contraste reducido en topografía sutil | Puede pasar por alto defectos en áreas extensas, menos eficaz para la inspección de patrones, más difícil de interpretar en áreas complejas. |
Progresión del grado de pulido para alcanzar las especificaciones de rayado y excavación deseadas
El proceso de pulido utiliza una progresión de grados abrasivos para conseguir las especificaciones de rayado deseadas para los componentes ópticos. Los ingenieros empiezan con abrasivos gruesos para eliminar los daños subsuperficiales y, a continuación, pasan a grados más finos para minimizar las imperfecciones superficiales y alcanzar la calidad de superficie requerida. El pulido final con abrasivos submicrónicos garantiza que el disco cumpla las estrictas normas estéticas y funcionales para aplicaciones láser.
Cada etapa de la secuencia de pulido reduce el tamaño y el número de defectos superficiales. Por ejemplo, el uso de abrasivos de diamante de 9-3 μm elimina los defectos más profundos, mientras que el óxido de cerio de 1-3 μm elimina los arañazos residuales. El paso final con <1 μm de óxido de cerio produce superficies que cumplen los niveles de especificación 40-20 o incluso 20-10, según el control del proceso y el rigor de la inspección.
Resumen de los pasos clave para alcanzar el objetivo Scratch-Dig:
Empezar con abrasivos gruesos para eliminar los daños subsuperficiales.
Progresión a abrasivos más finos para el refinamiento de la superficie.
Acabado con pulido submicrónico para obtener superficies de alta calidad listas para el láser.
¿Qué especificaciones de pulido de rugosidad superficial definen un acabado de calidad óptica?
La rugosidad superficial desempeña un papel vital a la hora de determinar la calidad de la superficie de los discos de cuarzo para óptica de precisión. Los ingenieros utilizan especificaciones ópticas estrictas para controlar las imperfecciones de la superficie y conseguir acabados de alta calidad para aplicaciones láser. Los cuidadosos protocolos de inspección e inspección visual ayudan a mantener una planitud y rugosidad superficiales uniformes en todos los componentes ópticos.
Normas de medición de la rugosidad superficial según ISO 10110-8
La norma ISO 10110-8 establece el estándar para medir la rugosidad superficial en óptica de precisión. Los ingenieros utilizan la interferometría de luz blanca y la microscopía de fuerza atómica para evaluar la superficie e identificar las imperfecciones que pueden afectar al rendimiento óptico. Estos métodos proporcionan datos precisos sobre la rugosidad de la superficie, lo que permite una inspección y un control de calidad fiables.
Los valores de rugosidad superficial de los discos de cuarzo suelen oscilar entre Ra <5 nm para uso óptico general y Ra <1 nm para aplicaciones láser. La interferometría de luz blanca capta la textura de frecuencia espacial media a alta, mientras que la microscopía de fuerza atómica ofrece una resolución vertical subnanométrica. Los ingenieros confían en estas técnicas para garantizar que cada disco cumple la especificación requerida y supera la inspección visual.
En un cuadro recapitulativo se destacan las principales normas de medición y su repercusión en la calidad de la superficie:
Estándar | Método de medición | Efecto sobre la calidad |
|---|---|---|
ISO 10110-8 | Interferometría de luz blanca, AFM | Datos precisos de rugosidad superficial |
Ra <5 nm | Óptica general | Reduce la dispersión y mejora la transmisión |
Ra <1 nm | Aplicaciones láser | Minimiza la pérdida de luz y mejora el rendimiento |
Relación entre la dispersión total integrada (TIS) y la rugosidad superficial
La dispersión total integrada (TIS) describe cómo afecta la rugosidad de la superficie a la cantidad de luz dispersada por un disco de cuarzo pulido. Los ingenieros utilizan los cálculos de TIS para predecir el rendimiento óptico y establecer especificaciones para la rugosidad de la superficie. La relación entre TIS y rugosidad es fundamental para los sistemas láser y de imagen.
El TIS depende de varios factores, como la rugosidad RMS, la longitud de onda y el ángulo de incidencia. La ecuación TIS_BP(Rq) = R0[1-e^{-(4πRq cos θi/λ)^2}] muestra que una mayor rugosidad aumenta la dispersión, lo que reduce la calidad del componente óptico. Por ejemplo, una superficie con Ra = 5 nm dispersa más luz que una con Ra = 1 nm, lo cual es esencial para aplicaciones láser de alta precisión.
Frases clave del resumen:
Una menor rugosidad superficial reduce el TIS y mejora las especificaciones ópticas.
Los ingenieros utilizan los cálculos del TIS para fijar objetivos de calidad superficial.
La medición precisa de la rugosidad garantiza un rendimiento fiable del láser.
Parámetros de pulido que optimizan el logro de una rugosidad ultrabaja
Los ingenieros optimizan los parámetros de pulido para conseguir una rugosidad superficial ultrabaja en discos de cuarzo. El superpulido y el pulido químico-mecánico (CMP) son dos técnicas eficaces para minimizar las imperfecciones superficiales y cumplir estrictas especificaciones ópticas. Estos métodos utilizan abrasivos especializados y condiciones controladas para producir superficies con una rugosidad RMS inferior a 0,1 nm.
El superpulido alcanza una rugosidad RMS inferior a 0,1 nm, lo que reduce la dispersión de la luz y mejora la calidad de la imagen. CMP utiliza aditivos y partículas abrasivas optimizadas para alcanzar valores de rugosidad tan bajos como 0,124 nm. Las nuevas lechadas ácidas de SiO2 pueden aumentar los índices de eliminación hasta 900%, alcanzando valores de Ra cercanos a 0,193 nm. Los ingenieros seleccionan la técnica adecuada en función de la especificación y la aplicación requeridas.
Un cuadro sinóptico presenta los métodos de pulido más eficaces y sus resultados:
Técnica de pulido | Parámetros clave | Rugosidad superficial alcanzada |
|---|---|---|
Superpulido | Rugosidad RMS < 0,1 nm | < 0.5 Å |
CMP | Aditivos, abrasivos optimizados | 0,124 nm |
Lodos ácidos de SiO2 | Mayor índice de eliminación | Ra 0,193 nm |
¿Qué especificaciones de daño subsuperficial (SSD) del disco de cuarzo requieren el control del proceso de pulido?
Los daños subsuperficiales (SSD) pueden comprometer la calidad superficial de la óptica y reducir el rendimiento de los discos de cuarzo de precisión. Los ingenieros deben controlar los SSD mediante un pulido y una inspección cuidadosos para cumplir las estrictas especificaciones de las aplicaciones ópticas y láser. Una medición y documentación fiables ayudan a mantener una alta calidad superficial y evitan que las imperfecciones de la superficie afecten al rendimiento del sistema.
Métodos de medición de daños en la subsuperficie: Destructivo frente a no destructivo
Los métodos de medición de las DSS se dividen en dos categorías principalesdestructivas y no destructivas. Las técnicas destructivas, como la microscopía de sección transversal, proporcionan una caracterización directa y cuantitativa de la profundidad de los SSD, pero requieren la destrucción de la muestra y llevan mucho tiempo. Los métodos no destructivos, como las pruebas magnetorreológicas de puntos de acabado y la medición interferométrica de la profundidad, ofrecen una evaluación eficaz y de bajo coste, pero puede que no proporcionen tantos detalles.
Los ingenieros seleccionan el método adecuado en función de las especificaciones requeridas y el volumen de producción. Los ensayos destructivos son adecuados para ópticas láser críticas en las que la precisión es esencial, mientras que los enfoques no destructivos funcionan bien para la inspección rutinaria y la supervisión de procesos. Ambos métodos contribuyen a mantener la calidad de la superficie y garantizan que la SSD permanezca dentro de límites aceptables.
Cómo determinan los parámetros de rectificado la profundidad inicial del SSD
Los parámetros de rectificado influyen mucho en la profundidad inicial de la SSD en la fabricación de discos de cuarzo. El tamaño de las partículas abrasivas desempeña un papel clave, ya que las partículas más grandes provocan un SSD más profundo y una mayor rugosidad superficial. Los resultados experimentales muestran que los tamaños de abrasivo de diamante de 5 μm, 15 μm y 20 μm producen diferentes profundidades de SSD, e investigaciones anteriores confirman una correlación positiva entre la profundidad de SSD y la rugosidad de la superficie.
Los ingenieros ajustan los parámetros de rectificado para minimizar los SSD y mejorar la planitud de la superficie. Al seleccionar abrasivos más finos y optimizar la velocidad de rectificado, reducen el riesgo de imperfecciones superficiales y mejoran la calidad general del componente óptico. Un control cuidadoso durante el esmerilado sienta las bases para un pulido satisfactorio y una alta calidad superficial.
La selección de los parámetros de rectificado influye tanto en la profundidad SSD como en la rugosidad de la superficie, por lo que es un paso fundamental para conseguir especificaciones de precisión.
Frases clave del resumen:
Los abrasivos más finos reducen la profundidad SSD y la rugosidad superficial.
La velocidad de rectificado optimizada mejora la planitud de la superficie.
Un control adecuado del rectificado mejora la calidad óptica.
Requisitos para la eliminación completa de las SSD
El pulido debe eliminar suficiente material para eliminar el SSD y lograr la calidad de superficie requerida para la óptica. Los ingenieros determinan el arranque mínimo de material analizando la profundidad inicial de SSD y estableciendo objetivos de proceso basados en la especificación y la aplicación. Para la óptica láser, la eliminación de 15-25 μm de material durante el pulido garantiza que el SSD no comprometa el rendimiento ni introduzca imperfecciones en la superficie.
La inspección continua durante el pulido ayuda a verificar que el SSD se ha eliminado por completo. Los ingenieros utilizan la inspección interferométrica y visual para confirmar que la superficie cumple los requisitos de planitud y rugosidad superficial. La documentación adecuada contribuye a garantizar la calidad y proporciona trazabilidad para aplicaciones de precisión.
¿Qué especificaciones de pulido de calidad de cantos evitan la degradación del rendimiento?
La calidad de los bordes desempeña un papel crucial en el mantenimiento del rendimiento de los componentes ópticos de precisión. Unas especificaciones bien definidas para las dimensiones del chaflán, los límites de viruta y el acabado de los bordes ayudan a evitar imperfecciones superficiales que pueden degradar los resultados de los sistemas ópticos y láser. La inspección y el control adecuados de las características de los bordes garantizan que cada disco de cuarzo cumpla la especificación de calidad de superficie requerida.
Especificaciones de las dimensiones del chaflán para la protección de cantos
Las dimensiones de los chaflanes protegen el borde de un disco de cuarzo de astillamientos y daños mecánicos. Los ingenieros especifican chaflanes con anchuras entre 0,3 mm y 1,0 mm en un ángulo de 45 grados para distribuir la tensión y reducir el riesgo de grietas. Los sistemas automatizados de biselado con diamante mantienen las tolerancias del bisel dentro de ±0,1 mm, lo que reduce los índices de daños en los bordes inducidos por la manipulación de 6,5% a 1,2% durante la producción.
Un chaflán bien ejecutado evita las esquinas afiladas que pueden actuar como puntos de inicio de grietas o astillas. Este tratamiento de los bordes también ayuda a mantener la calidad de la superficie del disco hasta la abertura transparente, lo que favorece un rendimiento óptico uniforme. Los bordes biselados son especialmente importantes para los discos utilizados en aplicaciones láser, donde incluso las pequeñas imperfecciones de la superficie pueden afectar a la fiabilidad del sistema.
Frases clave del resumen:
La anchura y el ángulo del chaflán protegen contra daños en los bordes.
El biselado automatizado mejora la uniformidad y reduce los defectos.
Los bordes biselados permiten una alta calidad de superficie para uso óptico y láser.
Criterios de inspección de virutas en los bordes según ISO 10110-1
La inspección de virutas en los bordes sigue los criterios establecidos por la norma ISO 10110-1, que limita el tamaño máximo de las virutas a menos de 0,25 mm para la óptica de precisión. Los inspectores utilizan un microscopio de 10× para examinar el perímetro del disco e identificar cualquier astilla o grieta que supere la especificación. Los sistemas de inspección automatizados pueden mejorar aún más los índices de detección y reducir el riesgo de pasar por alto defectos.
Las virutas de tamaño superior al permitido crean puntos de concentración de tensiones, lo que aumenta la probabilidad de fractura durante la carga térmica o mecánica. El rechazo de discos con virutas de más de 0,15 mm ha evitado 95% de fallos de campo relacionados con fracturas iniciadas por el borde, según los datos de producción. Una inspección y documentación coherentes garantizan que sólo los discos que cumplen las especificaciones de calidad de los bordes llegan al montaje final.
Efectos de la dispersión de bordes en el rendimiento de la luz difusa del sistema óptico
La dispersión en los bordes puede introducir luz parásita no deseada en los sistemas ópticos, reduciendo la calidad de la imagen y la eficacia del sistema. Las grietas o astillas en el borde del disco provocan difracción de la luz, lo que genera luz parásita y degrada el rendimiento de los instrumentos de precisión. Los procesos de rectificado que crean grietas en los bordes aumentan aún más el riesgo de luz parásita al introducir imperfecciones adicionales en la superficie.
Los ingenieros minimizan la dispersión de los bordes especificando estrictos requisitos de calidad de los bordes y utilizando cuidadosos métodos de pulido e inspección. Este enfoque garantiza que la superficie permanezca libre de imperfecciones que puedan comprometer el sistema óptico.
¿Qué especificaciones de uniformidad de pulido del disco de cuarzo garantizan un rendimiento óptico constante?
Un rendimiento óptico constante depende de las estrictas especificaciones de uniformidad de pulido de los discos de cuarzo. La uniformidad garantiza que cada disco cumpla la especificación de superficie requerida y ofrezca resultados fiables en los exigentes sistemas láser y de imagen. Los ingenieros utilizan controles de proceso y métodos de inspección avanzados para minimizar las imperfecciones superficiales y mantener una alta calidad superficial.
Control estadístico de procesos (CEP) para operaciones de pulido
El control estadístico de procesos (SPC) ayuda a los ingenieros a supervisar y mantener la uniformidad del pulido durante la producción. Realizan un seguimiento de métricas clave como la variación del grosor, la planitud de la superficie y la conformidad del rayado en todos los lotes. Aplicando el SPC, los ingenieros pueden detectar rápidamente tendencias o desviaciones que podrían provocar imperfecciones en la superficie.
El SPC utiliza gráficos de control para visualizar la estabilidad del proceso e identificar resultados fuera de especificación. Por ejemplo, un valor Cpk de 1,33 o superior indica un proceso capaz, mientras que los valores por debajo de este umbral señalan la necesidad de tomar medidas correctivas. Los datos de más de 45.000 discos de cuarzo muestran que la implantación del SPC redujo la desviación estándar del grosor de 18 μm a 6 μm y mejoró el rendimiento de la primera pasada para la calidad scratch-dig de 89% a 96,5%.
El SPC garantiza que las operaciones de pulido produzcan discos con una superficie de alta calidad y mínimas imperfecciones.
Métrica clave | Causa | Efecto |
|---|---|---|
Variación del espesor | Desviación del proceso | Rendimiento óptico no uniforme |
Cpk ≥1.33 | Proceso estable | Alto rendimiento, baja tasa de rechazo |
Control SPC | Detección precoz | Menos imperfecciones superficiales |
Impacto del acondicionamiento de solapas en la uniformidad del pulido
El acondicionamiento de solapas afecta directamente a la uniformidad de la superficie pulida de los discos de cuarzo. Los ingenieros utilizan el acondicionamiento de solapas automatizado para mantener una textura superficial uniforme en la almohadilla de pulido, lo que ayuda a controlar las tasas de eliminación de material y la forma de la superficie. El pulido local con herramientas pequeñas permite controlar con precisión la cantidad de eliminación y la forma de la superficie, reduciendo el riesgo de imperfecciones superficiales.
El acondicionamiento regular de las vueltas evita el desgaste desigual y garantiza que cada disco reciba un tratamiento uniforme. Las técnicas de compensación de errores, como la detección y corrección en tiempo real de los errores de forma de la superficie, mejoran aún más la precisión del pulido. Estos métodos permiten a los ingenieros lograr una rugosidad superficial y una precisión de forma de nivel nanométrico, esenciales para los componentes ópticos de alta calidad.
El acondicionamiento de solapas sigue siendo un paso fundamental para cumplir las especificaciones de uniformidad de pulido de las exigentes aplicaciones láser y ópticas.
Resumen de los puntos clave:
El acondicionamiento automatizado de las rodillas mantiene la uniformidad de las almohadillas.
El pulido local de herramientas pequeñas mejora el control de la forma de la superficie.
Las técnicas de compensación de errores corrigen las desviaciones en tiempo real.
Requisitos de control ambiental para unos resultados de pulido uniformes
El control medioambiental desempeña un papel fundamental en la obtención de resultados de pulido uniformes y el mantenimiento de la calidad de las superficies. Los ingenieros regulan la temperatura, la humedad y la limpieza de la zona de pulido para evitar la desviación del proceso y la contaminación. Incluso pequeños cambios de temperatura, como una variación de ±5 °C, pueden alterar los índices de eliminación hasta en 20%, lo que da lugar a superficies no uniformes.
Un entorno controlado favorece reacciones químicas estables y una acción abrasiva uniforme durante el pulido. Las condiciones de sala limpia, con un mínimo de partículas en suspensión en el aire, ayudan a evitar la formación de nuevas imperfecciones en la superficie. Los datos de los controles automatizados del proceso muestran que mantener una temperatura de 22°C ±2°C y una concentración de pasta de 0,5% garantiza una calidad fiable de la superficie y reduce los índices de rechazo.
El control medioambiental garantiza que cada disco de cuarzo cumpla las especificaciones necesarias para su uso óptico y láser.
Factor medioambiental | Método de control | Resultado |
|---|---|---|
Temperatura | Mantener 22°C ±2°C | Tasas de eliminación estables |
Humedad | Regular para evitar la condensación | Acabado superficial uniforme |
Limpieza | Protocolos de salas blancas | Menos imperfecciones superficiales |
¿Qué normas de validación de calidad verifican las especificaciones de calidad del pulido y de la superficie?

Las normas de validación de calidad ayudan a los ingenieros a confirmar que los discos de cuarzo cumplen estrictas especificaciones ópticas. Estas normas utilizan una combinación de métodos de inspección, planes de muestreo y documentación para garantizar una calidad constante de la superficie. Una validación fiable protege las aplicaciones ópticas y láser de precisión de las imperfecciones superficiales.
Protocolos de inspección multitécnica para la caracterización completa de superficies
Los protocolos de inspección multitécnica proporcionan una visión completa de la superficie y ayudan a identificar imperfecciones que podrían afectar al rendimiento. Los ingenieros utilizan varios métodos, como mediciones de color y translucidez con un espectrofotómetro de reflectancia de doble haz, y calibran el dispositivo antes de cada sesión para garantizar la precisión. También examinan las caras de cuarzo pulido para comprobar el paralelismo con los planos del cristal y utilizan el análisis REA para determinar rugosidad superficial representativay que el tamaño del grano influye en la variabilidad de las mediciones.
Estos protocolos suelen incluir caracterización en un paso y en dos pasosEn los casos en que las aplicaciones de tintes y esmaltes revelan diferentes características de la superficie. Los rasgos de indentación observados durante la inspección pueden mostrar cómo la orientación cristalográfica influye en las propiedades superficiales. Combinando estas técnicas, los ingenieros obtienen un conocimiento profundo de la superficie y pueden resolver cualquier problema antes de la aprobación final.
Un enfoque multitécnico garantiza que cada disco cumpla la especificación requerida de calidad de superficie y soporte un rendimiento óptico fiable.
Frases clave del resumen:
Múltiples métodos de inspección revelan todas las imperfecciones de la superficie.
Los protocolos de calibración y medición mejoran la precisión.
El análisis de la rugosidad superficial depende del tamaño del grano de pulido.
Planes de muestreo estadístico según ISO 2859-1 para la inspección de la producción
Los planes de muestreo estadístico basados en la norma ISO 2859-1 ayudan a los ingenieros a inspeccionar eficazmente grandes lotes de discos de cuarzo. Estos planes utilizan niveles de calidad aceptables (NCA) para determinar cuántas muestras deben inspeccionarse y qué nivel de defectos es aceptable. Por ejemplo, un NCA de 1,5 significa que sólo 1,5% del lote puede tener imperfecciones antes de que se rechace el lote.
Los planes de muestreo reducen el tiempo de inspección al tiempo que mantienen altos niveles de calidad superficial. Los ingenieros seleccionan muestras al azar y comprueban que cumplen las especificaciones ópticas, como planitud, rayado y rugosidad. Si las muestras pasan, se acepta todo el lote; si no, es necesario realizar más inspecciones o tomar medidas correctivas.
Plan de muestreo | Causa | Efecto |
|---|---|---|
ISO 2859-1 | Define el tamaño de la muestra y el NCA | Garantiza una inspección eficaz de los lotes |
Selección aleatoria | Reduce los sesgos | Mejora la fiabilidad de los resultados |
Umbral de defectos | Establece las imperfecciones máximas permitidas | Mantiene la calidad de la superficie |
Requisitos de la documentación de certificación para la calidad de la superficie óptica
La documentación de certificación proporciona pruebas de que cada disco de cuarzo cumple la especificación requerida de calidad superficial. Los ingenieros recopilan informes certificados de composición de materiales y a menudo solicitan la verificación de terceros a organizaciones como SGS o TÜV para aplicaciones críticas. Estos documentos incluyen resultados de normas como ASTM E1245 para el mapeo de impurezas, MIL-PRF-13830B para la certificación de rayado y ISO 10110-7 para la cuantificación de imperfecciones superficiales.
Una documentación exhaustiva facilita la trazabilidad y la garantía de calidad durante todo el proceso de producción. También ayuda a los clientes a verificar que los discos cumplen todos los requisitos ópticos y láser. Al mantener registros detallados, los fabricantes pueden resolver rápidamente cualquier duda sobre la calidad o el rendimiento de sus productos.
La certificación garantiza que cada disco cumple las normas más estrictas de precisión y especificaciones ópticas.
Frases clave del resumen:
Los informes certificados confirman el cumplimiento de las normas de calidad de la superficie.
La verificación por terceros aumenta la confianza en las aplicaciones críticas.
La documentación apoya la trazabilidad y la garantía del cliente.
¿Cómo deben especificar los ingenieros los requisitos de pulido y calidad superficial para la contratación pública?
Los ingenieros deben definir requisitos claros y mensurables a la hora de adquirir discos de cuarzo para aplicaciones ópticas y láser. Deben utilizar notación y criterios de aceptación normalizados para evitar confusiones y garantizar resultados coherentes. Una especificación adecuada ayuda a evitar imperfecciones en la superficie y favorece la alta precisión en entornos exigentes.
Notación ISO 10110 para especificaciones inequívocas de calidad superficial
La notación ISO 10110 ofrece a los ingenieros un lenguaje universal para especificar los requisitos de las superficies. Este sistema utiliza una serie de números y símbolos para describir la planitud, la rugosidad, el rayado y otros parámetros críticos. Al utilizar ISO 10110, compradores y proveedores pueden comunicar sus expectativas sin ambigüedades.
Por ejemplo, una especificación podría decir "3/λ/4; 40-20; Ra <2nm", lo que significa un diámetro de prueba de 3 mm, planitud λ/4, rayado 40-20 y rugosidad superficial inferior a 2 nm. Esta notación permite la comparación directa entre proveedores y garantiza que todas las partes entienden la calidad superficial requerida. Los datos de las encuestas del sector demuestran que el uso de ISO 10110 reduce los errores de aprovisionamiento en 25% y acelera el proceso de aprobación en 18%.
Los ingenieros que utilizan la notación ISO 10110 ayudan a garantizar que todos los discos ópticos cumplen las especificaciones previstas.
Punto clave | Causa | Efecto |
|---|---|---|
Notación normalizada | Comunicación clara | Menos errores de contratación |
Parámetros detallados | Requisitos precisos | Mejora de la calidad de la superficie |
Sistema universal | Adopción por el sector | Proceso de aprobación más rápido |
Creación de criterios de aceptación de inspección con niveles NCA adecuados
Los ingenieros establecen criterios de aceptación de la inspección para controlar el número de imperfecciones admisibles en cada lote. Utilizan niveles de calidad aceptables (NCA) para definir cuántos defectos se permiten antes de rechazar un lote. Este método garantiza que sólo lleguen al montaje final los discos que cumplan las especificaciones de superficie requeridas.
Los niveles de NCA, como 1,5 o 2,5, determinan el tamaño de la muestra y el umbral de defectos para la inspección. Por ejemplo, un NCA de 1,5 significa que no más de 1,5% del lote puede tener imperfecciones. Los datos de producción demuestran que el uso de la inspección basada en el NCA reduce el riesgo de discos ópticos defectuosos en 30% y aumenta la satisfacción del cliente en aplicaciones láser.
Mediante el establecimiento de criterios de aceptación claros, los ingenieros mantienen una alta calidad superficial y precisión en cada envío.
Resumen de los pasos clave:
Definir los niveles de NCA en función del riesgo de la aplicación.
Utilice un muestreo aleatorio para comprobar las imperfecciones de la superficie.
Rechazar los lotes que superen el umbral de defectos permitido.
Los ingenieros consiguen un rendimiento óptimo en óptica de precisión siguiendo estrictas especificaciones de pulido y calidad superficial. El control minucioso de la planitud, rugosidad y acabado de los bordes de las superficies evita imperfecciones que pueden afectar a los sistemas ópticos y láser. La inspección y la documentación basadas en normas garantizan que cada superficie cumpla los requisitos de calidad. Los ingenieros y compradores deben especificar criterios claros para las superficies y utilizar una validación sólida para mantener una alta calidad superficial en todas las aplicaciones.
PREGUNTAS FRECUENTES
¿Qué significa la planitud de la superficie de los discos de cuarzo?
La planitud de la superficie describe la uniformidad del disco en comparación con un plano de referencia. Los ingenieros miden la planitud mediante interferometría. Una alta planitud garantiza el buen rendimiento del disco en sistemas ópticos.
¿Qué métodos de inspección de superficies verifican la calidad?
Los ingenieros utilizan herramientas de interferometría, microscopía y medición de la rugosidad. Estos métodos ayudan a detectar imperfecciones superficiales. Cada técnica proporciona datos para el control de calidad.
¿Qué especificaciones de superficie son críticas para las aplicaciones láser?
Los sistemas láser necesitan discos con baja rugosidad superficial, arañazos mínimos y planitud precisa. Los datos demuestran que Ra <1 nm y scratch-dig 20-10 mejoran el rendimiento del láser.
Consejo: Elegir la especificación de superficie adecuada reduce la luz parásita y aumenta la fiabilidad del sistema.
Especificación | Valor típico | Aplicación |
|---|---|---|
Planitud | λ/10 | Imágenes |
Rugosidad | Ra <2 nm | Láser |
Rascar y cavar | 40-20 | Óptica de precisión |
¿Qué características de calidad de los bordes evitan daños en la superficie?
Los bordes biselados y los estrictos límites de virutas protegen la superficie del disco. El biselado y la inspección automatizados reducen el riesgo de grietas. Estas características ayudan a mantener el rendimiento óptico.





